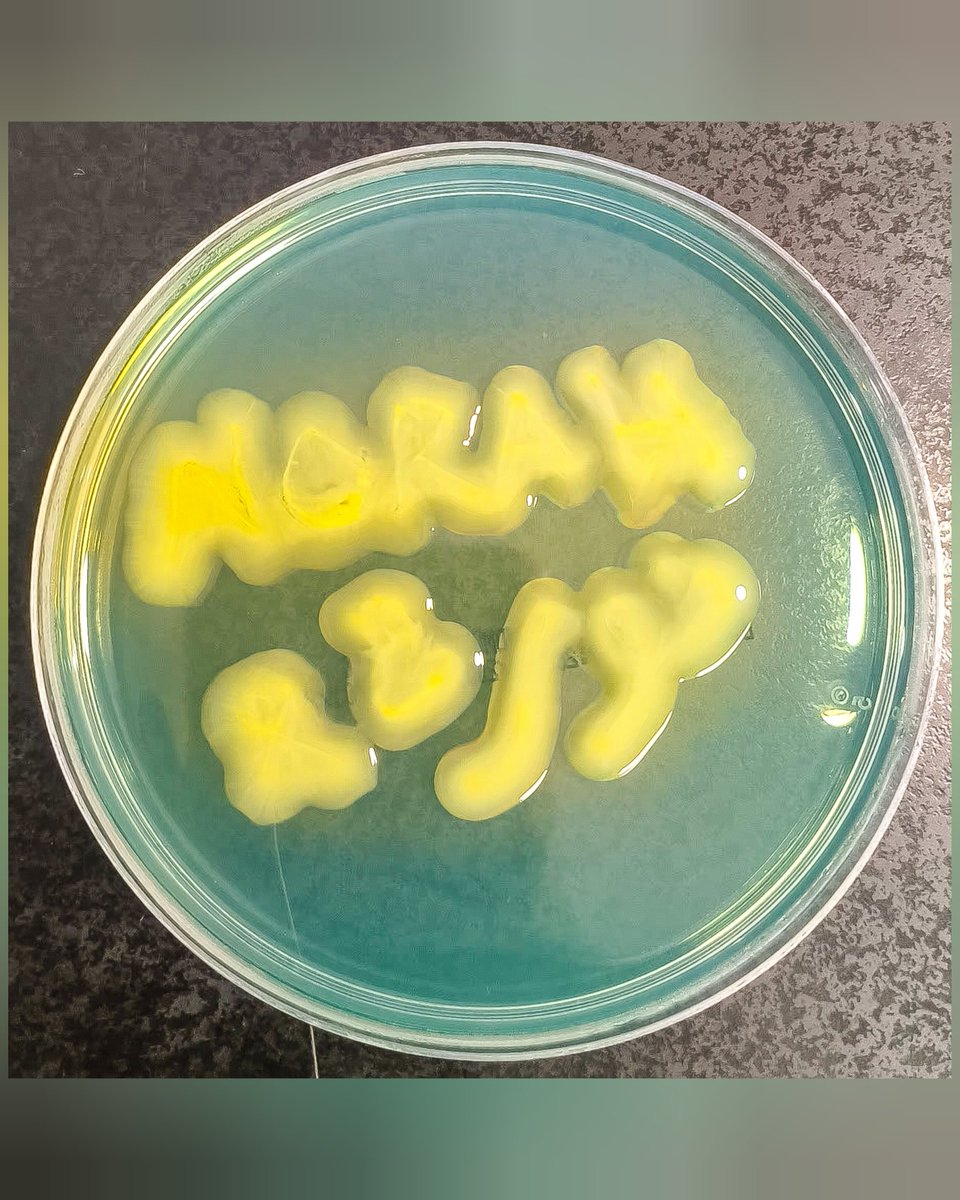
Norah Al-johani tweet media

Sabitlenmiş Tweet
Norah Al-johani
2.8K posts


Norah Al-johani
@MicrobioGirl
{رَبِّ ارْحَمْهُمَا كَمَا رَبَّيَانِي صَغِيرًا} Medical Microbiology | Graduate student. Tellonym الاستفسار تفضلوا التيل
Kingdom of Saudi Arabia Katılım Haziran 2023
947 Takip Edilen2.5K Takipçiler

#مايكروبيولجي جينوميات الممرض وتسلسل الجينوم الكامل: التقدم نحو تشخيص وعلاج أدق 🧫🧬
حققت جينوميات المُمْرِض (Pathogenomics) تطوراً تطبيقياً هائلاً في السنوات الأخيرة. فقد اتخذ العلماء والأطباء تقنية تسلسل الجينوم الكامل (Whole Genome Sequencing - WGS) أداة محورية تربط البيانات الوراثية بالطب السريري وعلم الأوبئة. يوظف المختصون هذه التقنية اليوم في التشخيص الدقيق والتتبع الوبائي وفهم آليات المقاومة والضراوة، لينقلوها من مختبرات الأبحاث النظرية إلى صميم التطبيق العملي المباشر للرعاية الصحية.
🔹ماهية تقنية تسلسل الجينوم الكامل (WGS)؟
هذه التقنية هي عملية قراءة شاملة للقواعد النيتروجينية للحمض النووي للكائن الممرض بمستوى تغطية عالي الكفاءة. يعتمد علماء الميكروبيولوجي على برمجيات المعلوماتية الحيوية (Bioinformatics) لتحديد سلالات الميكروبات وأنماطها الجينية، وكشف الجينات المسؤولة عن إحداث المرض أو مقاومة الأدوية.
يستهل خبراء المختبرات بروتوكول هذه التقنية باستخلاص الحمض النووي النقي من العينة، ليعقب ذلك خطوة تحضير المكتبة الجينية عبر تجزئة هذا الحمض وإضافة المكيفات (Adapters)، وهي عبارة عن قطع صغيرة اصطناعية من الحمض النووي تعمل كمقابض لربط العينة بأجهزة التسلسل لتمكينها من قراءتها، بالإضافة إلى المؤشرات الجزيئية. بعد ذلك، تعمل أجهزة الحاسوب المتقدمة على تحويل هذه الشفرة إلى بيانات رقمية، وتنفذ خوارزميات التجميع (Assembly) لإعادة بناء الجينوم، ليصل الطبيب في النهاية إلى تحديد نوع وسلالة الميكروب، والتنبؤ بخصائصه البيولوجية بدقة عالية.
🔹التطبيقات العملية في الرعاية الصحية:
•التشخيص الدقيق والتحديد النوعي
تتجاوز هذه التقنية الطرق التقليدية بتمكين الأطباء من تمييز السلالات والأنماط الجينية للممرض بدقة متناهية، مما يسرع رحلة التشخيص ويحد بشكل كبير من الأخطاء الطبية.
• الكشف عن المقاومة الجينية للمضادات الحيوية
ترسم هذه التقنية خريطة واضحة للجينات والعناصر المتنقلة المرتبطة بمقاومة الأدوية. يقدم هذا المستوى من التفصيل للأطباء تنبؤاً دقيقاً للمقاومة الظاهرية (Phenotype)، أي توقع كيف سيتصرف الميكروب فعلياً ضد الدواء داخل جسم المريض، مما يوجههم نحو اختيار المضاد الحيوي الأنسب لكل حالة.
•التتبع الوبائي وتحليل التفشيات
يستثمر خبراء مكافحة العدوى هذه البيانات في التحليل العرقي الجيني (Phylogenetic Analysis) ليقارنوا بين السلالات ويحددوا السلف المشترك لها. يدعم هذا الإجراء الفرق الطبية في تتبع مسارات الأوبئة داخل المستشفيات بدقة وتطبيق تدابير وقائية صارمة وفعالة.
• تحليل عوامل الضراوة (Virulence Factors)
يتمكن الباحثون عبر هذه التقنية من تحديد الجينات المسؤولة عن التصاق الميكروب بخلايا المريض، وإفرازه للسموم، واستخدامه للآليات المناعية المراوغة (Immune Evasion). يساعد هذا الفهم العميق الأطباء في تقييم الخطر السريري وتطوير علاجات تستهدف هذه الآليات بدقة.
🔹أمثلة حديثة من الواقع السريري:
أثبتت الدراسات الجينومية دور هذه التقنية الحاسم في فهم البكتيريا شديدة الخطورة. ففي دراسة تناولت سلالات المكورات العنقودية الذهبية المقاومة للميثيسيلين (MRSA)، نجح الباحثون عبر تقنية تسلسل الجينوم الكامل في تحديد العنصر الوراثي المتنقل (SCCmec) وجين المقاومة (mecA)، إلى جانب تحديد جينات الضراوة مثل hla وspa وicaA.
كما وظف العلماء التقنية بنجاح في تحليل سلالات الكليبسيلا الرئوية (Klebsiella pneumoniae) المقاومة للأدوية المتعددة؛ حيث مكنت قراءات التسلسل الباحثين من رسم خريطة وراثية دقيقة للبلازميدات (Plasmids)، التي تمثل جزيئات دائرية صغيرة من الحمض النووي تنقل جينات المقاومة والضراوة بين البكتيريا المختلفة، مما وجه المستشفيات لبناء استراتيجيات مكافحة عدوى بفاعلية أكبر.
🔹التحديات والآفاق:
يواجه القطاع الصحي تحديات عدة لتطبيق هذه التقنية بشكل روتيني، تشمل التكلفة المالية العالية، والحاجة الماسة لبنية تحتية رقمية قوية قادرة على معالجة البيانات الحيوية الضخمة، إضافة إلى ضرورة توظيف كوادر متخصصة في المعلوماتية الحيوية لتفسير النتائج المعقدة. متى ما تجاوزت المؤسسات الصحية هذه العقبات، ستصبح هذه التقنية معياراً يومياً أساسياً في جميع المختبرات السريرية.
🔹الخلاصة:
تمثل تقنية تسلسل الجينوم الكامل ركيزة أساسية ينهض عليها الطب الميكروبي المعاصر، إذ يتم تحويل البيانات الجينية المعقدة إلى معلومات سريرية ووبائية واضحة، مما يسرع اتخاذ القرارات العلاجية، ويحسن من برامج مكافحة العدوى، ويحد بخطوات استباقية من التهديدات المتزايدة للميكروبات المقاومة للأدوية.
* البوستر مصمم بالذكاء الاصطناعي

العربية

@SmaTrhwnt لفت نظري جمال اللون والخط 🧡🧡
ممكن اسم الكائن؟
قلت ممكن تكونRhodococcus أو Serratia
العربية

في كل عائلة لازم تلقى:
🕵️♂️ المحلل النفسي هانيبل اللي يسألك عن حالك ومشاعرك ويدقق بنبرة صوتك وحركة عينك وأنت تتكلم.
🔍 شيرلوك الفضولي اللي يسألك: كم عمرك؟ متى تتخرج؟ ومتى ناوي تشتغل؟ وما ينتظر إجابة بس كذا حاب يحقق.
👀 المدقق/ة اللي يراقب الملابس والمكياج والبيت والديكور وكل تفصيلة ويكتب تقييم شامل في السوشال ميديا بعدين.
المهم الله لا يحرمنا منهم😃
العربية
Norah Al-johani retweetledi

الأحيائي لا يكتفي بالقياس…
بل يحتفل بالنتيجة "وكل عام وانتم بخير "
الهرمونات في أعلى مستويات البهجة،ومعدّل النبض يميل للفرح والقلب في حالة امتنان مستقر🎂🎊
Norah Al-johani@MicrobioGirl
الأحيائي لا يقول: «عيدكم مبارك.» وإنما يقول: “المؤشرات الحيوية للمزاج مستقرة وتميل إلى التفاؤل، ولا حاجة لأي تدخل إضافي.” عيدكم مبارك 💚
العربية